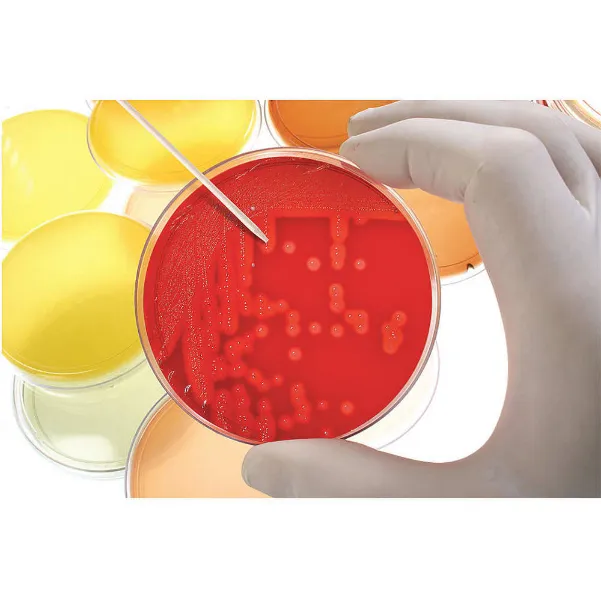
HEATHROW SCIENTIFIC HS120112 Test Tube Rack Polypropylene Blue | AH2BFJ 24EN48

FREE delivery on orders over €150
Product Specifications:
| Item | Test Tube Rack |
| Autoclavable | Yes |
| Color | Magenta |
| Compartment Length | 5/8" |
| Dimensions | 9.8" x 5" x 2.7" |
| For Use With | Tube |
| Height | 10" |
| Length | 5" |
| Material | Polypropylene |
| Mounting Location | Bench Top |
| No. Of Compartments | 72 |
| Overall Height | 10" |
| Overall Length | 5" |
| Overall Width | 2 7/8" |
| Product Type | Test Tube Rack |
| Total Holding Capacity | (72) Wells |
| Tube Size | 5 mL to 10 mL |
| Well Dia. | 16 mm |
| Wells | 72 |
| Width | 2 7/8" |
Shipping Info:
| Ship weight (kg) | 0.22 |
| Ship height (cm) | 25.4 |
| Ship length (cm) | 12.7 |
| Ship width (cm) | 7.3 |
| Country of Origin | CN |
Product Variants
| Product | Model | For Use With | Material | Color | Overall Width | Overall Height | Overall Length | Tube Size | Autoclavable | Pkg. Qty. | Price | |
|---|---|---|---|---|---|---|---|---|---|---|---|---|
 |
HS120085 | Plastic Tubes And Bottles | Wire | Blue | 2 1/2" | 6 1/2" | - | 25 mm | Yes | 1 | €38.12 | |
 |
HS120086 | Plastic Tubes And Bottles | Wire | Blue | - | - | - | 25 mm | Yes | 1 | €70.70 | |
 |
HS120087 | Plastic Tubes And Bottles | Wire | Blue | 3 1/8" | 2 3/8" | 8 3/8" | 33 mm | Yes | 1 | €38.12 | |
 |
HS120088 | Plastic Tubes And Bottles | Wire | Blue | 7 1/2" | 2 3/8" | 14" | 33 mm | Yes | 1 | €77.56 | |
 |
HS120089 | Plastic Tubes And Bottles | Wire | Blue | 4 1/4" | 2 5/8" | 8 1/4" | 13 mm | Yes | 1 | €64.65 | |
 |
HS120091 | Plastic Tubes And Bottles | Wire | Blue | - | - | - | 58 mm | Yes | 1 | €122.66 | |
|
HS120112 | Tube | Polypropylene | White | 10" | 4 1/4" | 27 1/8" | 13 mm | Yes | 1 | €154.44 |
Explore Products
- REGAL 007620AS85 Drill and Tap, M5 x .8 Size, D4 Limit, 2 Flutes, Metric With TiCN Coating
- APPLETON ELECTRIC CPP4075GXQ Hazardous Lighting Fixture, Ceiling Mount, Power 400W
- LIFT-ALL EE2603NFX12 12 ft. Flat Eye and Eye - Type 3 Web Sling, Nylon, No. of Plies 2, 3 Inch W
- GENERAL ELECTRIC THFK236225WL Circuit Breaker Feed-thru 225 Amp 600vac 3p 25kaic@480v
- GORLITZ 511 Motor, 1/3 Hp
- MANITOWOC 7604213 Evaporator Assembly
- ZSI-FOSTER HM4012RIB Rubber Insert, 12 mm Size
Explore More
- KEYSHAFT
- Precision Screwdriver Sets
- Submersible Level Transmitters
- Squeegee Replacement Blades and Refills
- Window Locks and Hardware
- Cap Nails
- PS DOORS Access Hatches
- ANVIL AS651 Series Reversible Strut Brackets, Electro Galvanized
- PROTO Crowfoot Socket Set Drive
- GROVE GEAR NH Series, BM-D Style, 815 Size, Ironman Narrow Housing Worm Gear Reducers
- UNISTRUT P1100T Series Channels, 10 Feet
- SIOUX CHIEF PowerPEX ASTM F1960 Manifolds
Contact us
Contact your account manager right away to get personal advice.
We're available Monday through Friday, from 07:30 until 17:00.
HEATHROW SCIENTIFIC HS27552D Test Tube Rack Slots 72 x 16mm Magenta
€220.22 /pack


